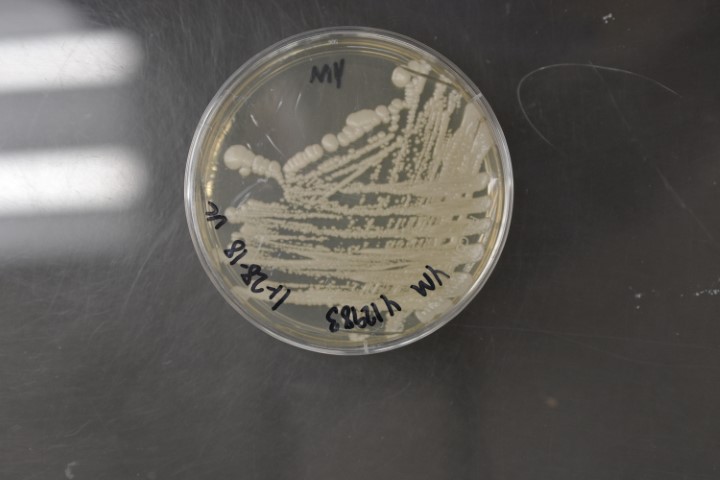

Candida albicans
NRRL Y-12983(Type Strain)
Accession numbers in other collections:ATCC 18804=CBS 562=CCRC 20512=CCY 29-3-104=CECT 1002=DBVPG 6133=IFO 1385=IGC 3436=JCM 1542=Mackinnon 572=NCYC 597
Source:David Yarrow,CBS,Delft,The Netherlands
Isolated from(substrate):CLN,skin infection,Erosio interdigitalis
Substrate location:Uruguay
Genetic info:Robnett PCR#94.GenBank:D1/D2(U45776).1 diff.D1/D2 with YB-3898,1 diff.D2 with Y-17967 1 diff.D2 with Y-17974,2 diff.D2 with Y-17976,2 diff.D1/D2 with Y-27022.
Growth media:Yeast Extract-Malt Extract-Peptone-Glucose(YM for yeasts)(number 6)
Optimum growth temperature:25C
Strain images:
NRRL_Y-12983_6.JPG

Comments:neotype strain,Lodderomyces-Spathaspora clade